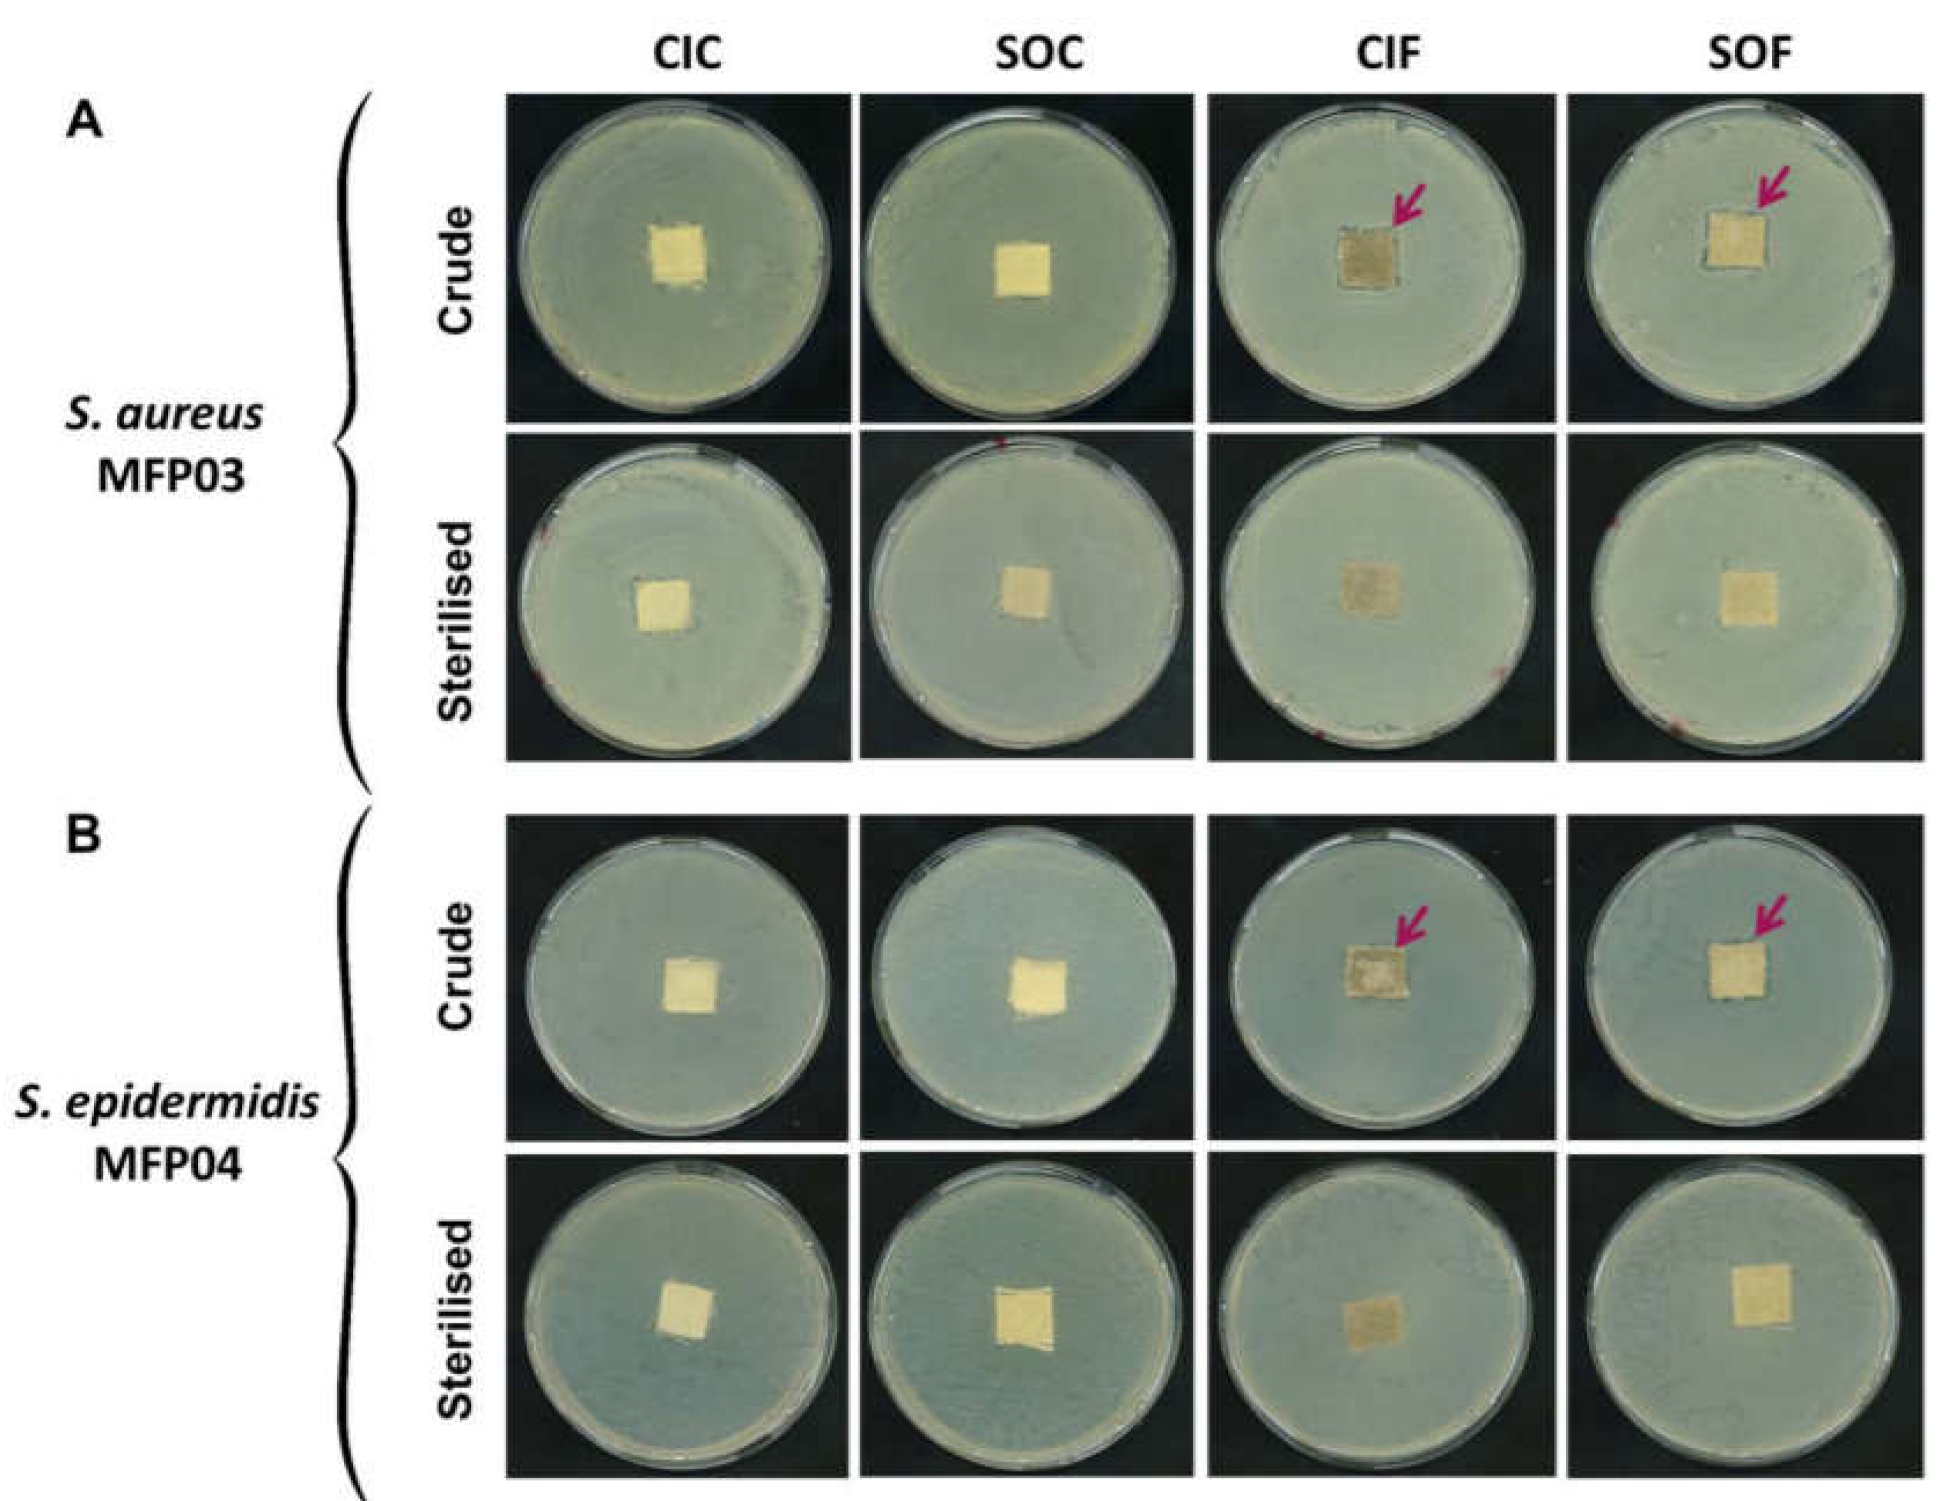
Life 12 00535 g001

Cotton and Flax Textiles Leachables Impact Differently Cutaneous Staphylococcus aureus and Staphylococcus epidermidis Biofilm Formation and Cytotoxicity
Abstract
1. Introduction
2. Materials and Methods
2.1. Textiles Samples
2.2. Bacterial Strains and Culture Conditions
2.3. Testing by Textiles Direct Contact
2.4. Bacterial Growth Kinetics
2.5. Measurement of Biofilm Formation Activity by Crystal Violet Staining
2.6. Confocal Laser Scanning Microscopy
2.7. Evaluation of Bacterial Biosurfactant Production
2.8. Characterization of the Bacterial Surface Polarity
2.9. Antibiotics Sensitivity Assay
2.10. Assessment of Bacterial Cytotoxicity and Inflammatory Activities
2.11. Chemical Analysis of Fabric Extracts
2.12. Statistical Analysis
3. Results
3.1. Effects of Crude and Sterilized Cotton and Flax Textiles on Staphylococcus aureus and Staphylococcus epidermidis Bacterial Lawns in Petri Dishes
3.2. Effects of Sterilized Cotton and Flax Textile Extracts on Staphylococcus aureus and Staphylococcus epidermidis Growth and Biofilm Formation
3.3. Effects of Cotton and Flax Textile Extracts on Staphylococcus aureus and Staphylococcus epidermidis on Biosurfactant Production and Surface Polarity
3.4. Effect of Cotton and Flax Extracts on Staphylococcus aureus and Staphylococcus epidermidis Resistance to Antibiotics, Cytotoxicity, and Inflammatory Potential
3.5. Cotton and Flax Extracts Analysis
4. Discussion
5. Conclusions
Author Contributions
Funding
Institutional Review Board Statement
Informed Consent Statement
Data Availability Statement
Acknowledgments
Conflicts of Interest
References
- Chen, Y.E.; Fischbach, M.A.; Belkaid, Y. Skin microbiota-host interactions. Nature 2018, 553, 427–436. [Google Scholar] [CrossRef]
- Al-Ghazzewi, F.H.; Tester, R.F. Impact of prebiotics and probiotics on skin health. Benef. Microbes 2014, 5, 99–107. [Google Scholar] [CrossRef] [PubMed]
- Sfriso, R.; Egert, M.; Gempeler, M.; Voegeli, R.; Campiche, R. Revealing the secret life of skin—With the microbiome you never walk alone. Int. J. Cosmet. Sci. 2020, 42, 116–126. [Google Scholar] [CrossRef] [PubMed]
- Grice, E.A.; Kong, H.H.; Conlan, S.; Deming, C.B.; Davis, J.; Young, A.C.; NISC Comparative Sequencing Program; Bouffard, G.; Blakesley, R.W.; Murray, P.R.; et al. Topographical and temporal diversity of the human skin microbiome. Science 2009, 324, 1190–1192. [Google Scholar] [CrossRef] [PubMed]
- Kong, H.H.; Segre, J.A. Skin microbiome: Looking back to move forward. J. Investig. Dermatol. 2012, 132, 933–939. [Google Scholar] [CrossRef]
- Patra, V.K.; Wagner, K.; Arulampalam, V.; Wolf, P. Skin microbiome modulates the effect of ultraviolet radiation on cellular response and immune function. iScience 2019, 15, 211–222. [Google Scholar] [CrossRef]
- Araviiskaia, E.; Berardesca, E.; Bieber, T.; Gontijo, G.; Viera, M.S.; Marrot, L.; Chuberre, B.; Dreno, B. The impact of airborne pollution on skin. J. Eur. Acad. Dermatol. Venereol. 2019, 33, 1496–1505. [Google Scholar] [CrossRef]
- Janvier, X.; Alexandre, S.; Boukerb, A.M.; Souak, D.; Maillot, O.; Barreau, M.; Gouriou, F.; Grillon, C.; Feuilloley, M.G.J.; Groboillot, A. Deleterious effects of an air pollutant (NO2) on a selection of commensal skin bacterial strains, potential cause of dysbiosis? Front. Microbiol. 2020, 11, 591839. [Google Scholar] [CrossRef]
- Souak, D.; Barreau, M.; Courtois, A.; André, V.; Duclairoir-Poc, C.; Feuilloley, M.G.J.; Gault, M. Challenging cosmetic innovation: Skin microbiota and probiotics to protect the skin from UV-induced damages. Microorganisms 2021, 9, 936. [Google Scholar] [CrossRef]
- Malcolm, S.A.; Hughes, T.C. The demonstration of bacteria on and within the stratum corneum using scanning electron microscopy. Br. J. Dermatol. 1980, 102, 267–275. [Google Scholar] [CrossRef]
- James, A.G.; Austin, C.J.; Cox, D.S.; Taylor, D.; Calvert, R. Microbiological and biochemical origins of human axillary odour. FEMS Microbiol. Ecol. 2013, 83, 527–540. [Google Scholar] [CrossRef] [PubMed]
- Callewaert, C.; Lambert, J.; Van de Wiele, T. Towards a bacterial treatment for armpit malodour. Exp. Dermatol. 2017, 26, 388–391. [Google Scholar] [CrossRef] [PubMed]
- Lam, T.T.H.; Verzotto, D.; Brahma, P.; Ng, A.H.Q.; Hu, P.; Schnell, D.; Tiesman, J.; Kong, R.; Ton, T.M.U.; Li, J.; et al. Understanding the microbial basis of body odor in pre-pubescent children and teenagers. Microbiome 2018, 6, 213. [Google Scholar] [CrossRef]
- Sattar, S.A.; Springthorpe, S.; Mani, S.; Gallant, M.; Nair, R.C.; Scott, E.; Kain, J. Transfer of bacteria from fabrics to hands and other fabrics: Development and application of a quantitative method using Staphylococcus aureus as a model. J. Appl. Microbiol. 2001, 90, 962–970. [Google Scholar] [CrossRef] [PubMed]
- Riley, K.; Williams, J.; Owen, L.; Shen, J.; Davies, A.; Laird, K. The effect of low-temperature laundering and detergents on the survival of Escherichia coli and Staphylococcus aureus on textiles used in healthcare uniforms. J. Appl. Microbiol. 2017, 123, 280–286. [Google Scholar] [CrossRef] [PubMed]
- Bajpai, V.; Bajpai, S.; Jha, M.K.; Dey, A.; Ghosh, S. Microbial adherence on textile materials: A review. J. Env. Res. Dev. 2011, 5, 666–672. [Google Scholar]
- Teufel, L.; Pipal, A.; Schuster, K.C.; Staudinger, T.; Redl, B. Material-dependent growth of human skin bacteria on textiles investigated using challenge tests and DNA genotyping. J. Appl. Microbiol. 2010, 108, 450–461. [Google Scholar] [CrossRef]
- Møllebjerg, A.; Palmén, L.G.; Gori, K.; Meyer, R.L. The bacterial life cycle in textiles is governed by fiber hydrophobicity. Microbiol. Spectr. 2021, 9, e0118521. [Google Scholar] [CrossRef]
- Zhong, W.; Xing, M.M.; Pan, N.; Maibach, H.I. Textiles and human skin, microclimate, cutaneous reactions: An overview. Cutan. Ocul. Toxicol. 2006, 25, 23–39. [Google Scholar] [CrossRef]
- Wollina, U.; Abdel-Naser, M.B.; Verma, S. Skin physiology and textiles—Consideration of basic interactions. Curr. Probl. Dermatol. 2006, 33, 1–16. [Google Scholar]
- Boryo, D.E.A. The effect of microbes on textile material: A Review on the way-out so far. Int. J. Eng. Sci. 2013, 2, 9–13. [Google Scholar]
- Sanders, D.; Grunden, A.; Dunn, R.R. A review of clothing microbiology: The history of clothing and the role of microbes in textiles. Biol. Lett. 2021, 17, 20200700. [Google Scholar] [CrossRef] [PubMed]
- Bockmühl, D. Hygiene aspects in domestic laundry. Hyg. Med. 2011, 36, 280–286. [Google Scholar]
- Hipler, U.-C.; Elsner, P. (Eds.) Biofunctional Textiles and the Skin. In Current Problems in Dermatology; Karger: Basel, Switzerland, 2006; Volume 33, pp. 67–77. [Google Scholar]
- Zuk, M.; Dorotkiewicz-Jach, A.; Drulis-Kawa, Z.; Arendt, M.; Kulma, A.; Szopa, J. Bactericidal activities of GM flax seedcake extract on pathogenic bacteria clinical strains. BMC Biotechnol. 2014, 14, 70. [Google Scholar] [CrossRef]
- Stabler, R.A.; Rosado, H.; Doyle, R.; Negus, D.; Carvil, P.A.; Kristjánsson, J.G.; Green, D.A.; Franco-Cendejas, R.; Davies, C.; Mogensen, A.; et al. Impact of the Mk VI skinsuit on skin microbiota of terrestrial volunteers and an international space station-bound astronaut. Microgravity 2017, 3, 23. [Google Scholar] [CrossRef]
- Dave, G.; Aspegren, P. Comparative toxicity of leachates from 52 textiles to Daphnia Magna. Ecotoxicol. Environ. Saf. 2010, 73, 1629–1632. [Google Scholar] [CrossRef]
- Chen, H.L.; Burns, L.D. Environmental analysis of textile products. Cloth. Text. Res. J. 2006, 24, 248–261. [Google Scholar] [CrossRef]
- Mijouin, L.; Hillion, M.; Ramdani, Y.; Jaouen, T.; Duclairoir-Poc, C.; Follet-Gueye, M.L.; Lati, E.; Yvergnaux, F.; Driouich, A.; Lefeuvre, L.; et al. Effects of a skin neuropeptide (Substance P) on cutaneous microflora. PLoS ONE 2013, 8, e78773. [Google Scholar] [CrossRef]
- N’Diaye, A.; Gannesen, A.; Borrel, V.; Maillot, O.; Enault, J.; Racine, P.-J.; Plakunov, V.; Chevalier, S.; Lesouhaitier, O.; Feuilloley, M.G. Substance P and Calcitonin Gene-Related Peptide: Key Regulators of cutaneous microbiota homeostasis. Front. Endocrinol. 2017, 8, 15. [Google Scholar] [CrossRef]
- Gannesen, A.V.; Lesouhaitier, O.; Racine, P.-J.; Barreau, M.; Netrusov, A.I.; Plakunov, V.K.; Feuilloley, M.G.J. Regulation of monospecies and mixed biofilms formation of skin Staphylococcus aureus and Cutibacterium acnes by human natriuretic peptides. Front. Microbiol. 2018, 9, 2912. [Google Scholar] [CrossRef]
- Gannesen, A.V.; Borrel, V.; Lefeuvre, L.; Netrusol, A.I.; Plakunov, V.K.; Feuilloley, M.G.J. Effect of two cosmetic compounds on the growth, biofilm formation activity and surface properties of acneic strains of Cutibacterium acnes and Staphylococcus aureus. MicrobiologyOpen 2018, 8, e00659. [Google Scholar] [CrossRef] [PubMed]
- Fournière, M.; Latire, T.; Souak, D.; Feuilloley, M.G.J.; Bedoux, G. Staphylococcus epidermidis and Cutibacterium acnes: Two major sentinels of the skin microbiota and influence of cosmetics. Microorganisms 2020, 8, 1752. [Google Scholar] [CrossRef] [PubMed]
- Utkina, T.M.; Popova, L.P.; Kartashova, O.L.; Khazeeva, G.D.; Khaliullina, A.A. Phenotypical characteristics and genetical determinants of pathogenicity of Staphylococcus aureus, isolated form bacterial carriers, residing on the territories with various levels of anthropogenic pollution of air environment. Zh. Mikrobiol. Epidemiol. Immunobiol. 2015, 4, 35–40. [Google Scholar]
- Peng, H.; Zhang, Y.; Palmer, L.D.; Kehl-Fie, T.E.; Skaar, E.P.; Trinidad, J.C.; Giedroc, D.P. Hydrogen sulfide and reactive sulfur species impact proteome S-sulfhydration and global virulence regulation in Staphylococcus aureus. ACS Infect. Dis. 2017, 3, 744–755. [Google Scholar] [CrossRef]
- Lashi, A.; Senhal, N.; Alarcon, A.; Barcelo, B.; Caire-Maurissier, F.; Delaire, M.; Feuilloley, M.; Genot, S.; Lacaze, C.; Pisarik, L.; et al. Container-content compatibility studies—A pharmaceutical team’s integrated approach. PDA J. Pharm. Sci. Technol. 2009, 63, 285–293. [Google Scholar]
- Hillion, M.; Mijouin, L.; Jaouen, T.; Barreau, M.; Meunier, P.; Lefeuvre, L.; Lati, E.; Chevalier, S.; Feuilloley, M. Comparative study of normal and sensitive skin aerobic bacterial populations. MicrobiologyOpen 2013, 2, 953–961. [Google Scholar] [CrossRef]
- Janvier, X.; Boukerb, A.M.; Feuilloley, M.G.J.; Groboillot, A. Draft genome sequences of four commensal strains of Staphylococcus and Pseudomonas isolated from healthy human skin. Microbiol. Resour. Announc. 2021, 10, e01032-20. [Google Scholar] [CrossRef]
- O’Toole, G.A. Microtiter dish biofilm formation assay. J. Vis. Exp. 2011, 47, 2437. [Google Scholar] [CrossRef]
- Berry, J.D.; Neeson, M.J.; Dagastine, R.R.; Chan, D.Y.C.; Tabor, R.F. Measurement of surface and interfacial tension using pendant drop tensiometry. J. Colloid Interface Sci. 2015, 454, 226–237. [Google Scholar] [CrossRef]
- Bellon-Fontaine, M.; Rault, J.; Van Oss, C. Microbial adhesion to solvents: A novel method to determine the electron-donor/electron-acceptor or Lewis acid-base properties of microbial cells. Colloids Surf. B Biointerfaces 1996, 7, 47–53. [Google Scholar] [CrossRef]
- EUCAST Disk Diffusion Test Methodology. Disk Diffusion. Manual v 9.0. 2021. Available online: https://eucast.org/ast_of_bacteria/disk_diffusion_methodology (accessed on 2 March 2022).
- Picot, L.; Chevalier, S.; Abdelmoula, S.; Merieau, A.; Guerillon, J.; Leroux, P.; Cazin, L.; Orange, N.; Feuilloley, M.G.J. Cytotoxic effects of the Pseudomonas fluorescens lipopolysaccharide in neurons and glial cells. Microb. Pathog. 2003, 35, 95–106. [Google Scholar] [CrossRef]
- Carrillo, C.; Teruel, J.A.; Aranda, F.J.; Ortiz, A. Molecular mechanism of membrane permeabilization by the peptide antibiotic surfactin. Biochim. Biophys. Acta 2003, 1611, 91–97. [Google Scholar] [CrossRef]
- Groboillot, A.; Portet-Koltalo, F.; Le Derf, F.; Feuilloley, M.G.J.; Orange, N.; Poc, C.D. Novel Application of cyclolipopeptide amphisin: Feasibility study as additive to remediate polycyclic aromatic hydrocarbon (PAH) contaminated sediments. Int. J. Mol. Sci. 2011, 12, 1787–1806. [Google Scholar] [CrossRef] [PubMed]
- Borrel, V.; Gannesen, A.V.; Barreau, M.; Gaviard, C.; Duclairoir-Poc, C.; Hardouin, J.; Konto-Ghiorghi, Y.; Lefeuvre, L.; Feuilloley, M.G.J. Adaptation of acneic and non acneic strains of Cutibacterium acnes to sebum-like environment. MicrobiologyOpen 2019, 9, e00841. [Google Scholar] [CrossRef]
- UE Regulation 1007/2011 of the European Parliament and of the Council. Textile Fibre Names and Related Labelling and Marking of the Fibre Composition of Textile Products and Repealing Council Directive 73/44/EEC and Directives 96/73/EC and 2008/121/EC of the European Parliament and of the Council Text with EEA Relevance. 2011. Available online: https://eur-lex.europa.eu/legal-content/EN/TXT/?uri=celex%3A32011R1007 (accessed on 2 March 2022).
- UE Regulation. Clothing and Textiles Regulations in the European Union: A Complete Guide. Available online: https://www.compliancegate.com/european-union-clothing-textiles-regulations/ (accessed on 2 March 2022).
- Carraro, V.; Sanna, A.; Pinna, A.; Carrucciu, G.; Succa, S.; Marras, L.; Bertolino, G.; Coroneo, V. Evaluation of microbial growth in hospital textiles through challenge test. Adv. Exp. Med. Biol. 2021, 1323, 19–34. [Google Scholar]
- ISO 20645:2004-12; Textile Fabrics—Determination of Antibacterial Activity—Agar Diffusion Plate Test. International Organization for Standardization: Geneva, Switzerland, 2004; p. 9. Available online: https://www.iso.org/standard/35499.html (accessed on 2 March 2022).
- AATCC 147; Test Method for Antibacterial Activity of Textile Materials: Parallel Streak. American Association of Textile Chemists and Colorists (AATCC): Triangle Park, NC, USA, 2016; p. 3. Available online: https://members.aatcc.org/store/tm147/554/ (accessed on 2 March 2022).
- Racine, P.-J.; Janvier, X.; Clabaut, M.; Catovic, C.; Souak, D.; Boukerb, A.M.; Groboillot, A.; Konto-Ghiorghi, Y.; Duclairoir-Poc, C.; Lesouhaitier, O.; et al. Dialog between skin and its microbiota: Emergence of “Cutaneous Bacterial Endocrinology”. Exp. Dermatol. 2020, 29, 790–800. [Google Scholar] [CrossRef]
- Khan, M.A.; Wahid, A.; Ahmad, M.; Tahir, M.T.; Ahmed, M.; Ahmad, S.; Hasanuzzaman, M. World Cotton Production and Consumption: An Overview. In Cotton Production and Uses; Ahmad, S., Hasanuzzaman, M., Eds.; Springer Nature: Singapore, 2020; pp. 1–7. [Google Scholar]
- Styrczewska, M.; Kostyn, A.; Kulma, A.; Majkowska-Skrobek, G.; Augustyniak, D.; Prescha, A.; Czuj, T.; Szopa, J. Flax fiber hydrophobic extract inhibits human skin cells inflammation and causes remodeling of extracellular matrix and wound closure activation. Biomed. Res. Int. 2015, 2015, 862391. [Google Scholar] [CrossRef]
- Zimniewska, M.; Goślińska-Kuźniarek, O. Evaluation of antibacterial activity of flax fibres against the Staphylococcus aureus bacteria strain. Fibres Text. East Eur. 2016, 24, 120–125. [Google Scholar] [CrossRef]
- Borrel, V.; Thomas, P.; Catovic, C.; Racine, P.-J.; Konto-Ghiorghi, Y.; Lefeuvre, L.; Duclairoir-Poc, C.; Zouboulis, C.C.; Feuilloley, M.G.J. Acne and stress: Impact of catecholamines on Cutibacterium acnes. Front. Med. 2019, 6, 155. [Google Scholar] [CrossRef]
- Ferrigno, S.; Guadagnini, R.; Tyrell, K. Is Cotton Conquering its Chemical Addiction? A Review of Pesticide Use in Global Cotton Production; Pesticide Action Network: Brighton, UK, 2018; 76p, Available online: https://issuu.com/pan-uk/docs/cottons_chemical_addiction_-_update?e=28041656/62705601 (accessed on 2 March 2022).
- Bhatt, P.; Verma, A.; Gangola, S.; Bhandari, G.; Chen, S. Microbial glycoconjugates in organic pollutant bioremediation: Recent advances and applications. Microb. Cell Fact. 2021, 20, 72. [Google Scholar] [CrossRef]
- Bouffartigues, E.; Moscoso, J.A.; Duchesne, R.; Rosay, T.; Fito-Boncompte, L.; Gicquel, G.; Maillot, O.; Bénard, M.; Bazire, A.; Brenner-Weiss, G.; et al. The absence of the Pseudomonas aeruginosa OprF protein leads to increased biofilm formation through variation in c-di-GMP level. Front. Microbiol. 2015, 6, 630. [Google Scholar] [CrossRef] [PubMed]
- Lequette, Y.; Greenberg, E.P. Timing and localization of rhamnolipid synthesis gene expression in Pseudomonas aeruginosa biofilms. J. Bacteriol. 2005, 187, 37–44. [Google Scholar] [CrossRef] [PubMed]
- Hay, I.D.; Gatland, K.; Campisano, A.; Jordens, J.Z.; Rehm, B.H. Impact of alginate overproduction on attachment and biofilm architecture of a supermucoid Pseudomonas aeruginosa strain. Appl Environ. Microbiol. 2009, 75, 6022–6025. [Google Scholar] [CrossRef] [PubMed]
- Gulot, E.; Georges, P.; Brun, A.; Fontaine-Aupart, M.P.; Bellon-Fontaine, M.N.; Briandet, R. Heterogeneity of diffusion inside microbial biofilms determined by fluorescence correlation spectroscopy under two-photon excitation. Photochem. Photobiol. 2002, 75, 570–578. [Google Scholar] [PubMed]
- Dagorn, A.; Hillion, M.; Chapalain, A.; Lesouhaitier, O.; Poc, C.D.; Vieillard, J.; Chevalier, S.; Taupin, L.; Le Derf, F.; Feuilloley, M.G.J. Gamma-aminobutyric acid acts as a specific virulence regulator in Pseudomonas aeruginosa. Microbiology 2013, 159, 339–351. [Google Scholar] [CrossRef]
- Salunkhe, D.K.; Do, J.Y.; Maga, J.A. Biogenesis of aroma constituents of fruits and vegetables. CRC Crit. Rev. Food Sci. Nutr. 1979, 8, 161–190. [Google Scholar] [CrossRef]
- Meyer, B.K.; Ni, A.; Hu, B.; Shi, L. Antimicrobial preservative use in parenteral products: Past and present. J. Pharm. Sci. 2007, 96, 3155–3167. [Google Scholar] [CrossRef]
- Konopásek, I.; Strzalka, K.; Svobodova, J. Cold shock in Bacillus subtilis: Different effects of benzyl alcohol and ethanol on the membrane organization and cell adaptation. Biochim. Biophys. Acta 2000, 1464, 18–26. [Google Scholar] [CrossRef][Green Version]
- Yano, T.; Miyahara, Y.; Morii, N.; Okano, T.; Kubota, H. Pentanol and benzyl alcohol attack bacterial surface structures differently. Appl. Environ. Microbiol. 2016, 82, 402–408. [Google Scholar] [CrossRef]
- Hancock, R.E.W.; Scott, M.G. The role of antimicrobial peptides in animal defenses. Proc. Natl. Acad. Sci. USA 2000, 97, 8856–8861. [Google Scholar] [CrossRef]

| Antibiotics | Concentrations (µg) |
|---|---|
| Penicillin G | 1 |
| Erythromycin | 15 |
| Tetracyclin | 30 |
| Cefoxitin | 30 |
| Clindamycin | 2 |
| Chloramphenicol | 30 |
| Tobramycin | 10 |
| Kanamycin | 30 |
| Gentamycin | 10 |
| Ciprofloxacin | 5 |
| Ofloxacin | 5 |
| Trimethroprim-sulfamethoxazole | 25 |
| Levofloxacin | 5 |
| Norfloxacin | 10 |
| Trimethroprim | 5 |
| Moxifloxacin | 5 |
| Fusidic acid | 10 |
| Rifampicin | 5 |
| Aztreonam | 15 |
| Cephtazidim | 10 |
| Carbapenem | 100 |
| Vancomycin | 30 |
| Imipenem | 10 |
| Ticarcillin | 75 |
Publisher’s Note: MDPI stays neutral with regard to jurisdictional claims in published maps and institutional affiliations. |
© 2022 by the authors. Licensee MDPI, Basel, Switzerland. This article is an open access article distributed under the terms and conditions of the Creative Commons Attribution (CC BY) license (https://creativecommons.org/licenses/by/4.0/).
Share and Cite
Catovic, C.; Abbes, I.; Barreau, M.; Sauvage, C.; Follet, J.; Duclairoir-Poc, C.; Groboillot, A.; Leblanc, S.; Svinareff, P.; Chevalier, S.; et al. Cotton and Flax Textiles Leachables Impact Differently Cutaneous Staphylococcus aureus and Staphylococcus epidermidis Biofilm Formation and Cytotoxicity. Life 2022, 12, 535. https://doi.org/10.3390/life12040535
Catovic C, Abbes I, Barreau M, Sauvage C, Follet J, Duclairoir-Poc C, Groboillot A, Leblanc S, Svinareff P, Chevalier S, et al. Cotton and Flax Textiles Leachables Impact Differently Cutaneous Staphylococcus aureus and Staphylococcus epidermidis Biofilm Formation and Cytotoxicity. Life. 2022; 12(4):535. https://doi.org/10.3390/life12040535
Chicago/Turabian StyleCatovic, Chloé, Imen Abbes, Magalie Barreau, Catherine Sauvage, Jacques Follet, Cécile Duclairoir-Poc, Anne Groboillot, Sandra Leblanc, Pascal Svinareff, Sylvie Chevalier, and et al. 2022. "Cotton and Flax Textiles Leachables Impact Differently Cutaneous Staphylococcus aureus and Staphylococcus epidermidis Biofilm Formation and Cytotoxicity" Life 12, no. 4: 535. https://doi.org/10.3390/life12040535
APA StyleCatovic, C., Abbes, I., Barreau, M., Sauvage, C., Follet, J., Duclairoir-Poc, C., Groboillot, A., Leblanc, S., Svinareff, P., Chevalier, S., & Feuilloley, M. G. J. (2022). Cotton and Flax Textiles Leachables Impact Differently Cutaneous Staphylococcus aureus and Staphylococcus epidermidis Biofilm Formation and Cytotoxicity. Life, 12(4), 535. https://doi.org/10.3390/life12040535

